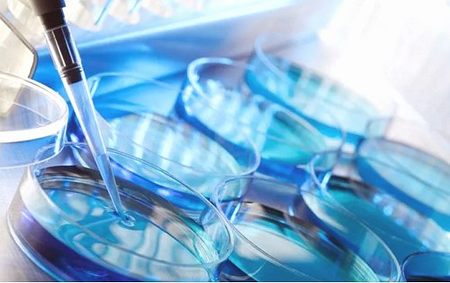

打了促排卵针几天可以移植了,促排卵针一般打几天就可以取卵了
- 疫苗
- 2023-06-25 07:35
有很多的女性表示已经打了上百针促排卵针,打了几天促排卵针,有没有像我一样不敢问医生,卵泡长得怎么样,有多少个,医生就说,在打三天针到时候再回来检查,我想看一下卵泡长得怎么样,医生说,快点去换鞋,过来在跟你说,我说,嗯,在打三天针,到时候回来找我,听她们两个交头,说用那么便宜的药,长得这样,已经很好了,我也不敢多问了,好想问什么时候可以取,有多少个,长得好不好,今天药多打手劈,有没有像我一样的
1、取卵后伤口要保持干净,伤口不需要拆线,只要揭下胶布就可以了。
2、在手术的过程中需要输入二氧化碳,所以在23天之内可能会有胀痛的感觉,但是这种情况是正常的,在取卵过后,或许还有少量的褐色分泌物。
3、在取卵的时候可能会给身体注射黄体素和HCG,取卵结束之后可能会出现血压下降,心跳加快,脸色苍白,或者是阴道出血的情况,这个时候需要到医院尽快的做紧急处理。
4、胚胎移植时候的疼痛感第3代试管婴儿是在取卵后的56天就可以进行胚胎移植了。在移植的过程中,女性可能会感觉到有一些不舒服的感觉,但是这种感觉并不会太疼。
打了促排卵针几天可以移植了
1、刚进手术室时我很紧张,因为一直听说取卵手术可能会很痛。
2、突然进入到一个陌生的环境,语言不通,而先生因为工作的关系需要晚几天才能到,我一个人到异国做手术,难免感到非常紧张。
3、促排卵针的针管很小,打的时候就一点点痛觉,促排卵针每天都要打,直到取卵手术。
4、10月15日,飞往泰国试管婴儿医院移植了1个男胚胎,在移植的7天后验孕成功了。
5、月经当天,我就坐上了飞往泰国的飞机,开始了泰国试管婴儿流程。
6、一站式海外试管婴儿助孕服务,会有你想要的答案!
7、8月20日:再次进行B超监测,有14个卵泡,医生安排当天晚上打了一支夜针,告诉我后天准备取卵手术。
8、医生说我的卵泡发育状况很好,减少了促排卵针剂的用量。
9、8月16日:医生进行B超监测卵泡,在我卵巢里监测到10个卵泡。
10、但20分钟后,手术结束,我都没有感受到预想中的痛苦。
11、流程,成功率等问题后,我们把这件赴泰的事情给确定下来了。
打了促排卵针几天可以移植了
1、我昨天去促排卵,医生给的鹿全丸和维E,我看这药好象男的吃的一样,心里寄了大的希望,今天早上吃下去了!
2、腹涨、尿尿少是卵巢过度刺激综合怔的表现之一。
3、反正这次最终还是没打,宝宝今年也没希望了。
4、唉我也打了,不过是先吃了克米再打hmg,只打了两针,也没有什么感觉。
5、我也是打这个针出血了,MM出血几天停止的?
取卵几天后可以移植
1、经期必须要干净以后才能够同房的,最好是在月经干净过24小时以后同房。
2、因为有时候在月经没干净,或者是干净24小时以内,阴道和宫腔还有血液,在这个时候过性生活有可能会出现经血的倒流,出现宫腔粘连或者是子宫内膜异位症,子宫腺疾病。
3、所以也很容易引起宫腔内感染的,对以后的怀孕和月经都是有影响的。
4、严重的话,还会出现慢性盆腔痛,由于此时宫颈的粘液栓还没有形成。
对于很多的女性来说,打促排卵针也是在可以承受的范围之内的皮下注射也没有那么疼,有很多的女性表示已经打了上百针促排卵针,肚皮上全是针眼,为了生出一个孩子,这样的痛苦也可以承受。

发表评论